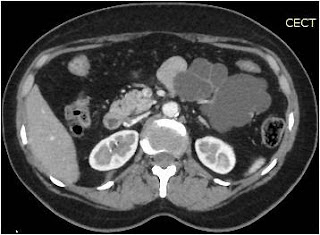
Serous Oligocystic Cystadenoma

Serous Oligocystic Cystadenoma
A 50 year lady presented with history of dull ache in left upper abdomen of 2 months duration. Her abdominal examination was unremarkable. The abdominal ultrasound was suggestive of cystic lesion in the body and tail of pancreas. The carbohydrate antigen 19-9 (CA 19-9) was 21 units/milliliter. Her other hematological & biochemical parameters were within prescribed normal range. Subsequently she underwent abdominal contrast enhanced computed tomography (CT) scan and then magnetic resonance cholangiopancreatography (MRCP) and contrast enhanced magnetic resonance imaging (MRI) scan (Figure A, B & C). In view of the typical imaging findings (vide infra) a diagnosis of SOA was made. Serous Oligocystic Cystadenoma
Figure A: Contrast enhanced abdominal computed tomography scan

Figure B: Contrast enhanced abdominal magnetic resonance imaging scan

Figure C: Magnetic Resonance Cholangio-Pancreatography
In line with current recommendation for surgery for pancreatic serous cystadenoma, resection was proceeded with due to symptomatic, large (> 4 cm) tumor.1
The patient underwent laparoscopy assisted distal pancreatectomy with splenectomy. At laparoscopy there was a large (approximately 9 x 7cm) multiloculated exophytic tumor in the body and tail region of pancreas that was adherent to the mesocolon and left branch of the middle colic artery (Figure D). She had an uncomplicated postoperative period and was discharged on 8th day following surgery. Histopathology revealed cysts lined by single layer of cuboidal epithelial cells filled with clear cytoplasm.

Figure D: Distal pancreatectomy + splenectomy specimen showing multiple thin walled cysts
Discussion
Serous oligocystic cystadenoma is a subgroup of pancreatic serous cystadenoma (SA) characterized by image findings described above.2 In comparison with SA, they are uncommon and can sometimes be difficult to diagnose due challenging overlap of image findings with other cystic lesions.
In the following sections, we present differentiating features with other pancreatic cystic neoplasms:
- Solid pseudopapillary neoplasm (SPN)
- Branch chain intraductal papillary mucinous neoplasm (IPMN)
- Mucinous cystic neoplasm (MCN)
In our patient, the contrast enhanced abdominal computed tomography scan shows a lobulated cystic neoplasm with septations in the body and tail of pancreas with thin (< 2 mm) non enhancing walls. The cystic spaces (6 in number) are > 2 cm (Figure A). These findings are better appreciated in contrast enhanced abdominal magnetic resonance imaging scan (Figure B). At magnetic resonance cholangio-pancreatography (MRCP), the main pancreatic duct (MPD) is not dilated in its entire course and there was no duct – cyst communication (Figure C). Hence a diagnosis of SOA was made.3
Mucinous cystic neoplasms usually are unilocular or mildly septated and have a smooth contour.3,4 The cyst wall is thick and enhances at contrast enhanced MR imaging.4
Branch chain IPMN was ruled out as the MPD was of normal caliber at MRCP and the cystic tumor did not have communication with the main pancreatic duct (Figure B).
Solid pseudopapillary neoplasms typically appear in young women and on contrast enhanced abdominal CT or MRI scan appear as well defined, encapsulated, heterogeneous solid and cystic tumor with areas with hemorrhagic degeneration.5 These findings are not consistent with those in Figures A and B from our patient. Therefore SPN was also ruled out.
References
- Tseng JF, Warshaw AL, Sahani DV et al. Serous Cystadenoma of the pancreas: tumor growth rates and recommendations for treatment. Ann Surg.2005;242(3):413-419
- Lee JH, Kim JK, Kim TH et al. MRI features of serous oligocystic adenoma of the pancreas: differentiation from mucinous cystic neoplasm of the pancreas. Br J Radiol. 2012;85:571-576
- Kim SY, Lee JM, Kim SH et al. Macrocystic neoplasms of the pancreas: CT differentiation of serous oligocystic adenoma from mucinous cystadenoma and intraductal papillary mucinous tumor. AJR. 2006;187:1192-1198
- Kalb B, Sarmineto JM< Kooby DA et al. MR imaging of cystic lesions of the pancreas. RadioGraphics 2009;29:1749-1765
Authors:
Dr Nitin Vashistha, MS, FIAGES, FACS
Dr Dinesh Singhal, MS, FACS, DNB (Surg Gastro)
Department of Surgical Gastroenterology,
Max Super Speciality Hospital, Saket, New Delhi, India
E mail: gi.cancer.india@gmail.com
gicancerindia.azurewebsites.net
- Cantisani V, Mortele KJ, Levy A et al. MR imaging features of solid pseudopapillary tumor of the pancreas in adult and pediatric patients. AJR. 2003;181:395-401

